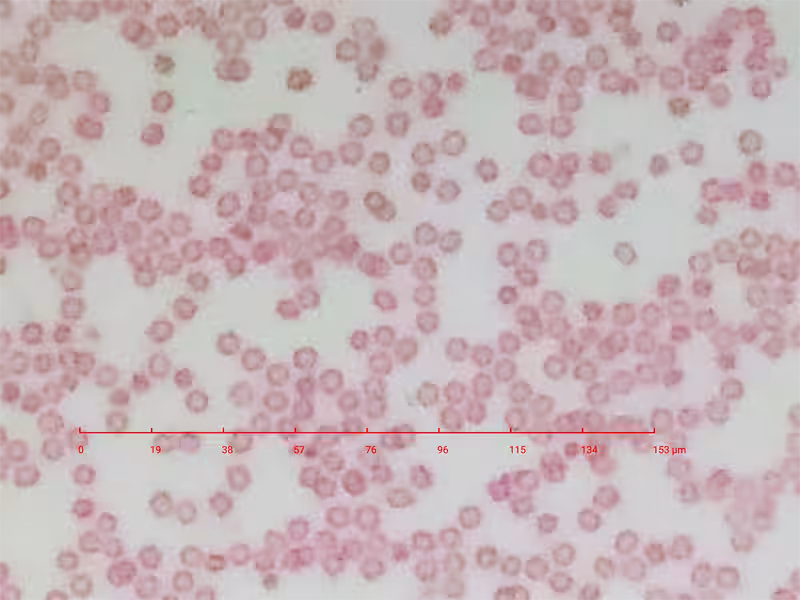
画像4

進化したスマホ顕微鏡『ミクロハンターMH-X250』が一般販売開始
進化したスマホ顕微鏡『ミクロハンターMH-X250』が一般販売開始
科学の新しいページを開くミクロの世界を手軽に体験できるツール、
『ミクロハンターMH-X250』の一般販売が始まりました。この新世代の顕微鏡レンズは
スマートフォンに簡単に装着でき、指先サイズでありながら光学250倍の倍率を実現。さらに、
スマホ機能を活用することで最大1200倍の観察が可能になることから、
身近なものを細部まで観察することができます。
新たな発見をもたらすツール
昨年1月に行われたクラウドファンディングでは、多数の支持を受け
多くの人々から「今まで見ていた世界がほんの数パーセントだとは!」という感動の声が
寄せられました。ユリの花粉や人の血球の観察が可能で、最大0.75μmの解像度を誇るこのレンズは、
科学教育やクリエイティブな用途にも最適です。子供たちや学生がミクロの世界を体験し、
科学への関心を深めるきっかけになることでしょう。
創造力を引き出すデバイス
『ミクロハンターMH-X250』は、ただの観察ツールにとどまらず、
創造力を刺激するデバイスです。アーティストたちは、ミクロの視点を通じて新しい
インスピレーションを得ることができるでしょう。小さなものを大きく見ることで、新たな発見が生まれ、
科学やアート、教育現場に革新をもたらすことでしょう。
購入と価格
この『ミクロハンターMH-X250』は、ミクロハンター公式ショップで
販売中で、価格は6,980円(税込)です。公式サイトで気軽に手に入れることができ、さまざまな
観察体験が待っています!公式サイトへのリンク: ミクロハンター公式ショップ
さらに深い体験を
現在、公式ショップでは4種類のレンズが販売されており、ミクロハンターキットMH-X250には
フォーカススタンドも付属されているため、より快適な観察が可能です。外出先や
教育現場でも使いやすく、持ち運びにも便利。
「身の回りの世界を、これまでにない視点で観察し、新しい発見をする楽しさを
多くの人に届けたい」という思いから、一般販売が始まりました。是非、この機会に
『ミクロハンターMH-X250』で新しい視点を体験してください。
会社概要
ビジネスを支える会社は、合同会社KaraSeedで、
東京都府中市白糸台に本社を構えています。私たちが日常の中で触れる世界の
新たな一面を見せてくれる『ミクロハンターMH-X250』をぜひお楽しみください。
製品公式ページ
詳細な情報はこちらからご覧いただけます:
製品公式ページ

会社情報
- 会社名
- 合同会社KaraSeed
- 住所
- 東京都府中市白糸台4-2-8
- 電話番号
トピックス(科学)










【記事の利用について】
タイトルと記事文章は、記事のあるページにリンクを張っていただければ、無料で利用できます。
※画像は、利用できませんのでご注意ください。
【リンクついて】
リンクフリーです。